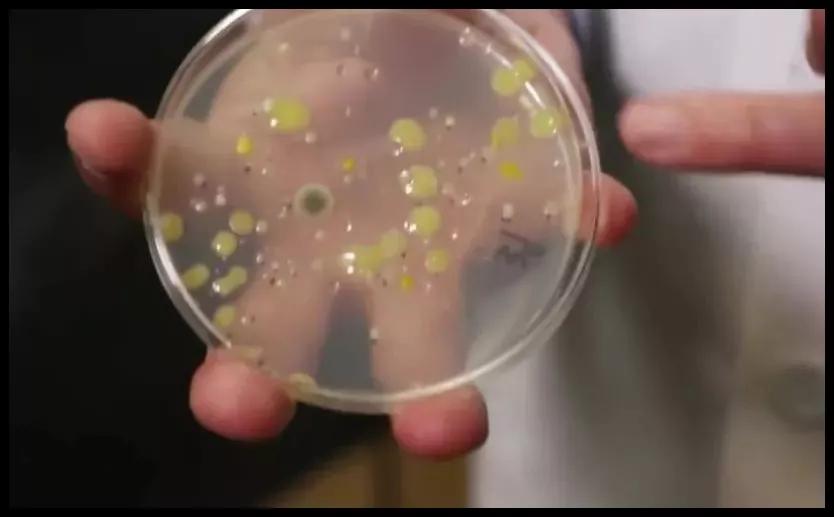
口红别人使用过的会携带细菌吗,专柜口红试用装会传染疾病吗
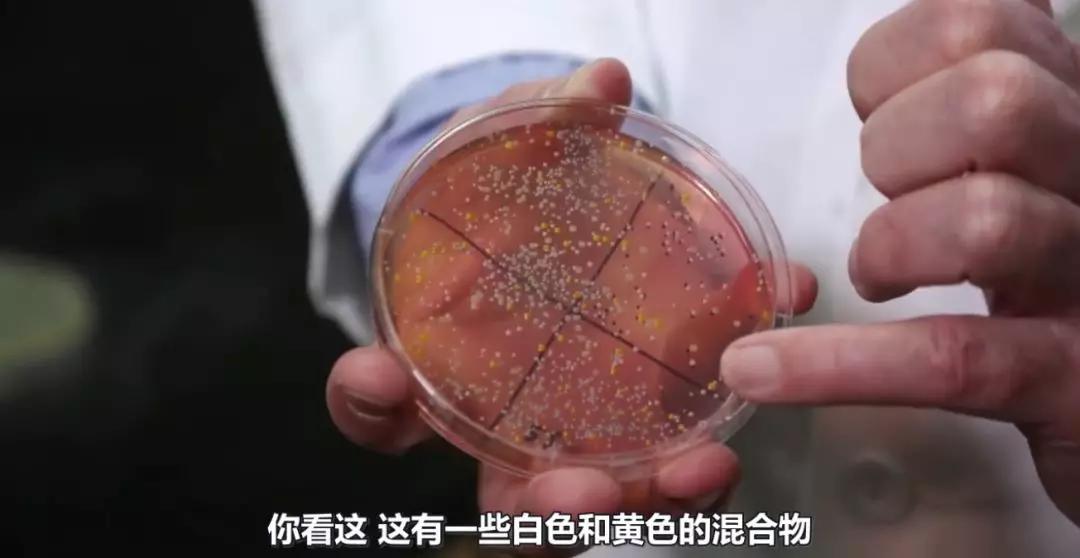
口红别人使用过的会携带细菌吗,专柜口红试用装会传染疾病吗
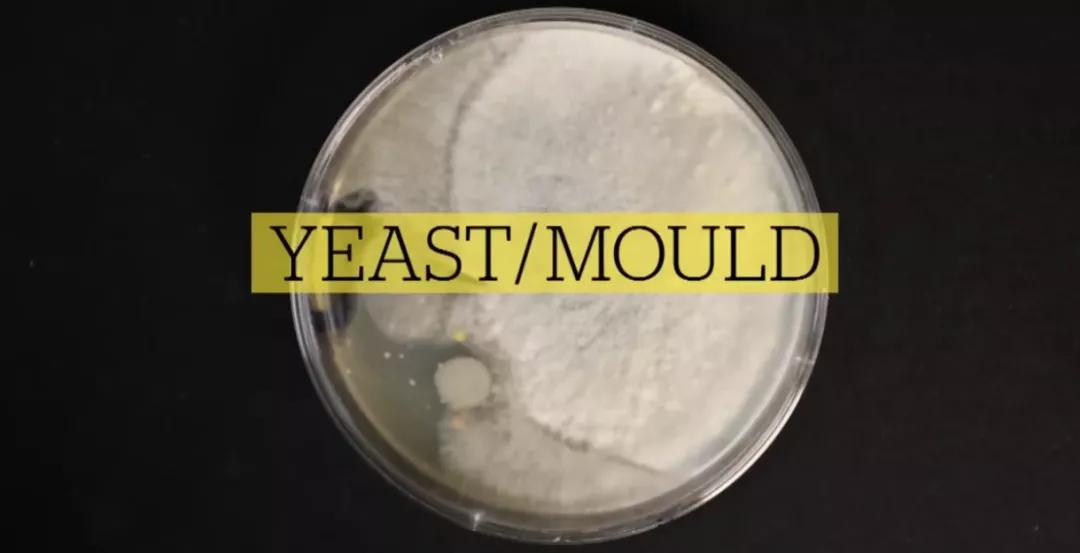
口红别人使用过的会携带细菌吗,专柜口红试用装会传染疾病吗
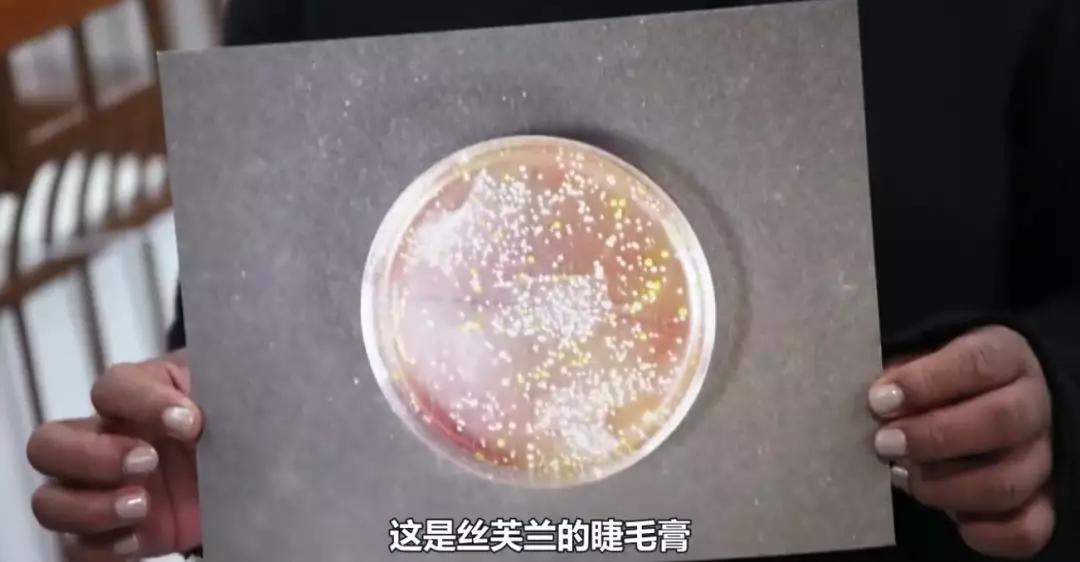
口红别人使用过的会携带细菌吗,专柜口红试用装会传染疾病吗

Hi,大家好
我是小梨阿姨
大家应该都知道我最近有勤奋上新了一些口红
(不知道的快去我店瞧瞧!)

销量还是挺出乎我的意料的哈哈
证明大家对于口红真的很狂热!
我都很认真拍照和尽量放无滤镜的试*图色**
但还是有几个小仙女收到觉得色号不合适自己
说想要退货的!我都果断拒绝的!!

(感谢这位亲理解)
因为一旦开封试用过,就会影响二次销售
谁也不愿意买别人试用过的口红吧!
而且试用过的化妆品已经是涉及卫生安全问题了!
不是我(公众号:小梨的护肤手记)危言耸听啊!
我最近看了一个纪录片
“Makeup:The dirty truth about testers”

(加拿大广播公司(CBC)录制)
下面跟你们分享一下↓
他们暗访了当地4个品牌的美妆连锁店:
丝芙兰(SEPHORA)、魅可(M.A.C)
美体小铺(THE BODY SHOP)、启康药房(SHOPPERS DRUG MART)
并且收集了店里的试用品,
拿去做检验
结果让人很崩溃。
试用化妆品有多脏?
我经常逛商场的化妆品专柜
都会发现不少姐姐阿姨直接上嘴涂口红


不知道你们有没有试过这些试用装呢?
节目中微生物学家凯斯·沃纳
给4家美妆店的60份试用品样品
做了一波检验

检验结果十分让人恶心
这些样品里面
大多数都有金黄色葡萄球菌
有一部分已经形成了霉菌
下面给大家好好介绍下
这些细菌
A 金黄色葡萄球菌
这种细菌能导致
湿疹、毛囊炎、局部化脓感染、
特应性皮炎加重等皮肤问题。
这次收集样品的4家店里,
全都检验出了金黄色葡萄球菌。
「这儿有一些白色和黄色的混合物。黄色的是金黄色葡萄球菌。其它那些乱七八糟的,可能导致各种各样的疾病。比如说红眼病等等。」沃纳说。
B 酵母菌/霉菌
如果你感染了这些病原菌,
皮肤可能会出现泛红、疼痛、水泡等问题。
如果它变成系统性问题,你还可能会发烧。
曲霉菌能释放出霉菌毒素,可能会导致霉尘肺。

C 大肠杆菌、单纯疱疹病毒、链球菌
更加恶心的来了!
美国「杰斐逊医学院」的一个研究小组
曾经花了两年时间,
收集百货公司、精品店专柜的试用化妆品,
检测细菌和病毒。
结果检出了大肠杆菌、单纯疱疹病毒、链球菌等。

(英国每日邮报的相关报道)
大肠杆菌通常寄居在人的肠道里,
通过粪便排出体外。

这意味着有人「方便」后不洗手,
直接把手指伸向了化妆品试用品。
「大肠杆菌」是导致人食物中毒的主要原因之一,感染者会胃痛、腹泻,严重甚至有生命危险。而感染「单纯疱疹病毒」,会让人口唇生疮。
柜姐难道都不清理的吗?
各大美妆店确实有要求店员
每天都要按时清洁
可事实上。。。
两个曾经在MAC、Sephora等
工作过的姑娘,曝光了真相

“
因为种类太多了。有很多人进店给自己化一套整妆,你不可能一直盯着她们。我们会在他们试用的时候,试着清理一下化妆刷或者试用品,但是坚持做下去还挺难的。
”

“
我在启康和美妆精品店上班时,并不会去清理试用品。我们做的唯一的清洁,也就是打扫卫生、清洁一下放香水的柜台,不会专门清理化妆品。
”
其实这也不能怪人家柜姐
我们大家都清楚
口红、眼影这类化妆品
真正清洁就是

当然,有的柜姐
也会拿出酒精喷雾
帮你做个简单的清洁
但是

用酒精喷雾
只能减少风险,不能消除风险
不能完全解决问题
而且用酒精湿润过的口红和眼影
基本都不能用了吧!
不试用,我怎么买到合适的呢?
小梨(公众号:小梨的护肤手记)给大家总结了一下

1. 不用公共化妆刷。
2. 不用其他顾客、导购用手直接接触过的化妆品。
3. 先用含酒精的清洁剂,清洁试用品。
4. 使用一次性棉签、刷子等一次性工具。
5. 在手背上试用。
6. 试用乳液等液体时,最好选择不需要用手指去蘸的那种。
7. 试用眼部、唇部等敏感部位的化妆品之后,一定要及时清洁。
8. 尝试索要个人试用装。
总之,
小梨建议大家不要随便去买闲鱼上的二手口红
也不要去专柜上嘴试口红
毕竟你不清楚
这些试用品被哪些人怎样试用过
可能是有口臭的大叔
可能嘴角还沾着孜然
也可能刚上完厕所。。。

-我还写了很多关于如何科学护肤的文章,还有很多小众 护肤品 的实测,想看的感兴趣的可以来我的公众号「小梨的 护肤手记 」